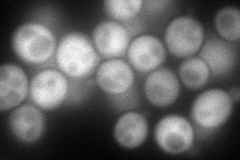
YIL142W
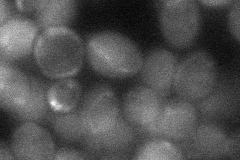
YIL142W

View description
Subunit beta of the cytosolic chaperonin Cct ring complex, related to Tcp1p, required for the assembly of actin and tubulins in vivo
Localization:
Intensity:
Fold change:
Significance:
-
C’ GFP library in SD

nucleus25.29 -
N' NOP1pr-GFP in SD
cytosol117.492 -
N' TEF2pr-mCherry in SD

cytosolN/A -
N' NATIVEpr-GFP in SD

cytosol,punctate24.8923 -
N' TEF2pr-VC and Cyto-VN in SD
cytosol32.9696 -
C’ GFP library in SD+DTT

nucleus25.711.01No -
C’ GFP library in SD+H2O2

nucleus21.190.83No -
C’ GFP library in Starvation Media

nucleus19.120.75Yes -
C’ GFP library on the background of Pup2-DaMP

nucleus -
C’ GFP library on the background of CCT mutant

nucleus27.74791.0965No
